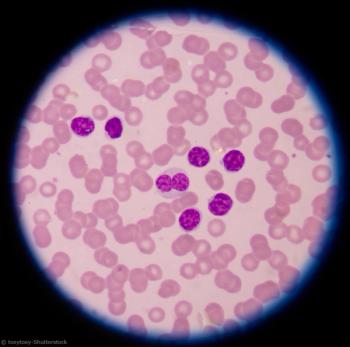

Can lenalidomide maintenance significantly improve progression-free survival in patients with newly diagnosed myeloma?

Your AI-Trained Oncology Knowledge Connection!


Can lenalidomide maintenance significantly improve progression-free survival in patients with newly diagnosed myeloma?

Treatment with pembrolizumab plus axitinib improved response and survival compared with sunitinib in patients with advanced, or metastatic clear-cell renal cell carcinoma.

African-American men with mCRPC may derive greater overall survival benefit from treatment with newer chemotherapies than Caucasian men.

A recent study showed oncologists lack knowledge, but are interested in receiving additional training to learn about the healthcare needs of LGBTQ patients.

A study investigates whether HPV testing performed on cervicovaginal samples self-collected by patients had a similar accuracy to samples collected by clinicians.

A retrospective study finds that younger mantle cell lymphoma patients may achieve longer PFS with AHCT consolidation.

Allogeneic transplantation was found not to improve overall outcome, in particular for patients who achieved MRD-negative status after induction.

A phase I study examines the use of LCAR-B38M, a CAR T-cell therapy directed against BCMA, in patients with relapsed/refractory multiple myeloma.

The study also looked at how lenalidomide maintenance further increases the rate of negative MRD results in multiple myeloma patients.

A study investigates whether FL patients had fewer early disease progression events when assigned to treatment with obinutuzumab plus chemotherapy.

Is the continuation of maintenance rituximab beneficial post bendamustine plus rituximab treatment in FL Patients?

A new computer algorithm was able to accurately analyze digital images of cervical screenings and identify precancerous changes that required further medical follow-up.

A meta-analysis looked at whether or not the sex of a patient had any association with the efficacy of immunotherapy in advanced cancers.

The highest rates of excess body weight–associated cancer were found in the South and Midwest, Alaska, and the District of Columbia, according to the study.

The thyroid screening program put in place after the 2011 Fukushima Daiichi nuclear power station accident resulted in the diagnosis of a number of pediatric thyroid cancers.

Negative colonoscopy results in patients with average CRC risk were associated with a lower risk for CRC diagnosis and death more than a decade after the test.

The XELAVIRI trial failed to demonstrate the noninferiority of a sequential escalation treatment strategy vs initial combination therapy in mCRC.

A study shows patients in the placebo group of clinical trials testing against targeted and immunotherapy cancer drugs may experience a high rate of grade 3/4 adverse events.

A study found follicular lymphoma patients staged with PET-CT and treated with radiotherapy appeared to have better outcomes than CT staging alone.

Despite improved outcomes seen in the rituximab era, the leading cause of death in patients with follicular lymphoma during the first decade remains lymphoma.

Delayed dose escalation may be an option for mRCC patients with concerns about drug-related toxicity or quality of life optimization.

A study found the gene mutations key in patients treated with first-line TKIs, and useful additions to a risk model that stratifies patients with mRCC.

A new study shows benefits in curative treatment approaches to secondary cancers among patients with myeloma.

Undergoing bloodless autologous stem cell transplantation could be a viable option for some multiple myeloma patients according to a retrospective study.

A patient’s minimal residual disease status may serve as a surrogate marker for outcome in clinical trials of chronic lymphocytic leukemia in patients with comorbidities.
Testing patterns associated with the diagnosis and treatment of chronic lymphocytic leukemia have changed rapidly during the last decade.

A new study has identified a clinically and biologically distinct subgroup of diffuse large B-cell lymphoma tumors.

A study looked at whether survivorship care plans were able to enhance patients' knowledge and adherence to physician recommendations.

Survey results published in JAMA Network Open looked at motivating factors behind patient travel and how far they were willing to go for treatment.

A study investigates whether R-CHOP is a viable first-line treatment for patients with advanced follicular lymphoma.